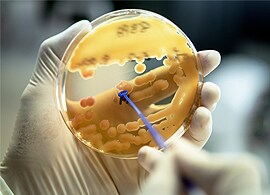
Ensuring detection of novel antimicrobial resistant strains – look out for Carbapenemases Ensuring detection of novel antimicrobial resistant strains – look out for Carbapenemases

Search
Search
Your newsletter is dedicated to exploring topics relating to antimicrobial susceptibility testing (AST), brought to you by our in-house experts. We look at everything from topics in the news, to emerging technology, pushing AST stewardship to the next level.
Have you signed up to our newsletter?
Minimum inhibitory concentration (MIC) results can play an important role in fighting antimicrobial resistance (AMR) and in guiding optimal clinical decisions. It’s too important to fail, but there is still some uncertainty about the best way to generate results. So, when does true mean true, what is a “definitive” MIC, and how does it provide the best path to right-first-time decisions?
How did the coronavirus pandemic contribute to antimicrobial resistance? Our new SmartNote Post-viral syndrome: Tackling the COVID-driven increase in AMR starts in the laboratory looks at the data behind the facts.
Interested in learning more about the latest 2022 CLSI and EUCAST updates? We consulted industry experts Dr. Romney Humphries and Professor Sören Gatermann on the highlights from this year’s report.
Curious about how a broth microdilution AST methodology would fit into your laboratory workflow? Explore how the University Hospital Southampton, UK, conducted a comparison study between the broth microdilution and disc diffusion methodologies and read about their experience with the Thermo Scientific™ Sensititre™ ARIS HiQ™ System for AST.
Apply the learnings of COVID to AMR, says coalition.
Tackling the deadly spectre of antimicrobial resistance (AMR) requires urgent, transformational, whole-system change.
In a new whitepaper, The Infection Management Coalition (IMC) claims that now is the time for the healthcare ecosystem to unite against the “existential threat” of resistance.
The development of antimicrobial resistance is part of natural evolutionary process among microorganisms, delivering beneficial traits in bacteria that protect the cell from the effects of specific antibiotics, thus conferring a survival advantage. However, the increased use, and misuse, of antimicrobials promotes the accelerated spread of resistance mechanisms, leading to the development of multi and pan-resistant bacteria that are untreatable with the antibiotics currently in use. The detection, correct diagnosis and treatment and surveillance of antimicrobial resistant organisms is key to fighting this growing global issue.
In recent years, awareness campaigns and policy decisions have contributed to a “better safe than sorry” approach to treating sepsis. However, such models mean patients may receive unnecessary antibiotics – a trend that can act as a contributing factor to the development of antimicrobial resistance (AMR).
Traditional methods of AST, which can define pathogens and guide right first-time treatment plans, can take up to 72 hours due to the requirement for overnight cultures. But new ways of doing things are emerging, and microbiologists are leading the charge.
Antibiotic use changed considerably during the first wave of SARS-CoV-2 as the pandemic changed processes and priorities almost overnight. We won’t know the true impact of this shift on antimicrobial resistance (AMR) for some time. But as the medical science community adapts to the ongoing threat of SARS-CoV-2, we need robust stewardship programmes that take account of these changing pathways and utilize all the tools at our disposal.
Infections originating from foodborne bacteria are becoming more challenging to treat due to increasing levels of antimicrobial resistance. The global One Health initiative in combatting AMR has resulted in various surveillance programs, including that set by European Commission and European Food Safety Authority.
Ready to implement a new antimicrobial susceptibility testing system into your laboratory? Even with a readymade solution, laboratories are often required to verify the performance of a new method in their own laboratory environment. Learn more about verification recommendations.
We all understand the importance of AST and MIC surveillance in the global AMR stewardship effort. We are well versed in this arena, but with new antibiotic cefiderocol’s unique mode of action, we require a unique method of MIC – one that involves different testing conditions to those used for existing treatment options.
Hear from our first guest editor, Professor Martha Clokie, as we explore the novel potential treasure trove of bacteriophages, taking a look back at past uses as well as looking forward to alternative therapies of the future.
Empiric antibiotic therapy in suspected bloodstream infections is vital. Unfortunately, a new study shows that discordant use is both fairly common, and potentially lethal. Knowing what data from the microbiology laboratory can help optimize the use of empiric therapy is essential to potentially saving lives.
View our webinar with renowned expert Dr. Rafael Canton, as he explores why rapid antimicrobial susceptibility testing is so important at a time when antibiotic resistance is growing into one of the biggest challenges the world faces today.
As we continue to adapt and respond to coronavirus, we’re also mindful of its potential connection to other life-threatening conditions, such as sepsis and the impact on antimicrobial resistance. Since the World Health Organization declared coronavirus a global health emergency, there is now more scientific data available to link coronavirus to sepsis.
It's World Quality Day, on November 12th, 2020. In order to celebrate a globally established event we’ve explored the connection between quality and antimicrobial susceptibility testing from the perspective of our business, as a manufacturer, and the products you use as a healthcare provider.
Three new Research Use Only (RUO) Thermo Scientific™ Sensititre™ plates for Nontuberculous Mycobacteria (NTM), provide the most up-to-date recognized drugs available to treat clinically significant NTMs1. In particular, the introduction of a new Nocardia format supports adoption of the latest CLSI guidelines for management of the immunocompromised patient groups most affected by infections related to this organism. The addition of the antibiotic Clofazimine, also provides additional guidance and treatment options in multi-drug resistant isolates. Find out more about these products and The World Health Organizations’ focus to end the TB epidemic by 2030.
The clinical microbiology team here at Thermo Fisher Scientific™ are in constant contact with healthcare workers dealing with coronavirus globally. Recently we received some important feedback which resulted in us supporting our customers implementing new testing workflows for coronavirus including adding Thermo Scientific™ Sensititre™ System testing options to support their laboratories increased demands for Candida albicans associated Ventilator Assisted Pneumonia (VAP). Visit the microbiology coronavirus support page.
Antibiotic resistance in anaerobes has been increasing for decades**, with recent focus on Moxifloxacin and most recently Carbapenems. EUCAST states that “Disk diffusion criteria for antimicrobial susceptibility testing of anaerobes have not yet been defined and an MIC method should be used"***. However, running individual MIC tests can be costly, slow and may end up reducing the number of therapeutic options available to patients suffering from intra-abdominal, genital tract, surgical site, brain abscesses and skin and soft tissue infections. A growing number of European hospitals are now testing 13 antibiotics in a single semi-automated test with full traceability.
Thermo Scientific™ Oxoid™ Ceftolozane/tazobactam C/T40 (product code CT1970B) discs are now available, and meet both the European Committee on Antimicrobial Susceptibility Testing (EUCAST) and the Clinical and Laboratory Standards Institute (CLSI) standards. Ceftolozane/tazobactam (ZERBAXA) is approved by the FDA in the United States and is indicated in adult patients for the treatment of complicated urinary tract infections (cUTI), and is also indicated for use in adult patients for the treatment of complicated intra-abdominal infections (cIAI). Both indications have been approved by the European Medicines Agency (EMA). ZERBAXA's latest label approval by the FDA includes hospital-acquired bacterial pneumonia (HABP) and ventilator-associated bacterial pneumonia (VABP), with EMA also reviewing this indication.
* CLSI. Susceptibility Testing of Mycobacteria, Nocardia spp., and Other Aerobic Actinomycetes. 3rd ed. CLSI standard M24. Wayne, PA: Clinical and Laboratory Standards Institute; 2018.
** Boyanova L, Kolarov R, Mitov I. Recent evolution of antibiotic resistance in the anaerobes as compared to previous decades. Anaerobe. 2015;31:4–10.
*** https://www.eucast.org/clinical_breakpoints/